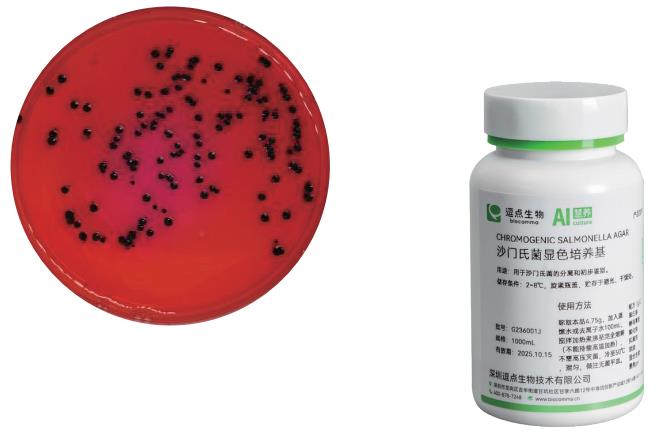
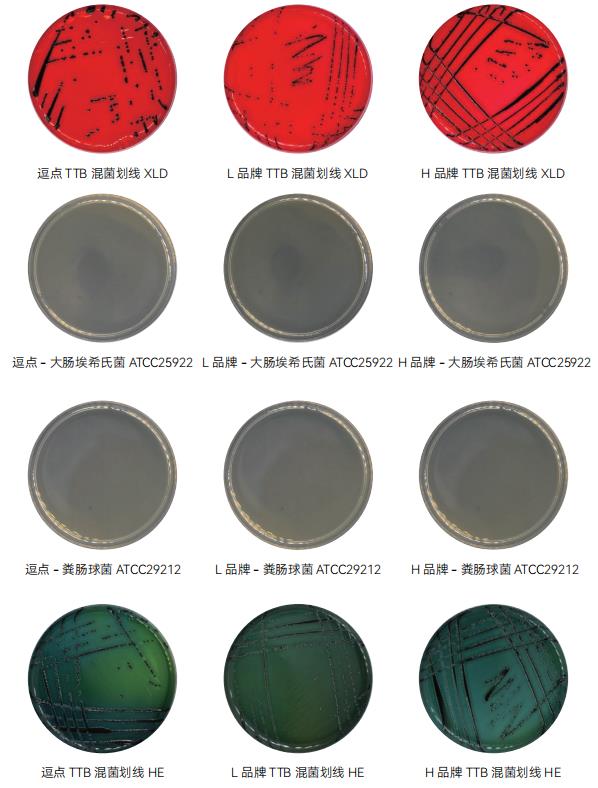
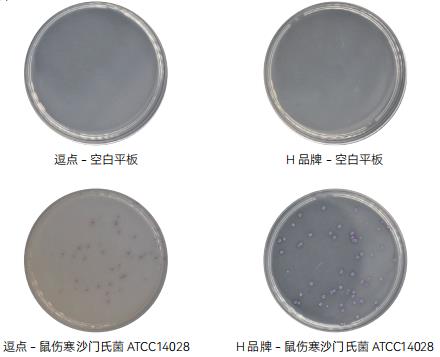

深圳市龙岗区吉华街道甘李六路12号中海信创新产业城12栋1楼

| 样品名称 | 质控菌株 | 厂家 | 待测培养基计数 | 菌液浓度计数(TSA) | 评定标准 | 结果判定 |
| 缓冲蛋白 胨水 (BPW) |
鼠伤寒 沙门氏菌 ATCC14028 |
逗点 | 820 | 27 |
取 10μl 增菌液倾注 TSA 平板 36℃±1℃培养 18h ~ 24h, 在 TSA 上>100CFU |
符合 |
| L 品牌 | 2291 | |||||
| 符合 | ||||||
| H 品牌 | 1905 | 符合 |

| 样品名称 | 质控菌株 | 厂家 | 待测培养基计数 | 菌液浓度计数(TSA) | 生长率(或特征) | 评定标准 | 结果判定 |
| 四硫磺 酸钠煌绿 (TTB) 增菌 |
鼠伤寒 沙门氏菌 ATCC14028 + 大肠埃希氏菌 ATCC25922 + 铜绿假单胞菌 ATCC27853 |
逗点 | / | 88 |
在 XLD 上>10Cfu 菌落无色半透明,有黑心 |
在 XLD 上 >10CFU 菌落无色 半透明, 有黑心 |
符合 |
| L 品牌 | / | 在 XLD 上>10Cfu 菌落无色半透明,有黑心 |
符合 | ||||
| H 品牌 | / | 在 XLD 上>10Cfu 菌落无色半透明,有黑心 |
符合 | ||||
| 大肠埃 希氏菌 ATCC25922 |
逗点 | 0 | 多不可计 |
<100 | 在 TSA 上 <100CFU |
符合 | |
| L 品牌 | 0 | <100 | 符合 | ||||
| H 品牌 | 0 | <100 | 符合 | ||||
| 粪肠球菌 ATCC29212 | 逗点 | 0 | 多不可计 |
<100 | 符合 | ||
| L 品牌 | 0 | <100 | 符合 | ||||
| H 品牌 | 0 | <100 | 符合 | ||||
| 1. 鼠伤寒沙门氏菌 ATCC14028+大肠埃希氏菌 ATCC25922+铜绿假单胞菌 ATCC27853 在四硫磺酸钠煌绿 (TTB)增菌上的菌落特征:菌落无色半透明,有黑心; 2. 大肠埃希氏菌 ATCC25922 在四硫磺酸钠煌绿(TTB)增菌上的菌落特征:在 TSA 上<100CFU; 3. 粪肠球菌 ATCC29212 在四硫磺酸钠煌绿(TTB)增菌上上的菌落特征:在 TSA 上<100CFU。 |
|||||||

| 样品名称 | 质控菌株 | 厂家 | 待测培养基计数 | 菌液浓度计数(TSA) | 生长率(或特征) | 评定标准 | 结果判定 |
| 亚硒酸 盐胱氨 酸增菌液 (SC) |
鼠伤寒 沙门氏菌 ATCC14028 + 大肠埃希氏菌 ATCC25922 + 铜绿假单胞菌 ATCC27853 |
逗点 | 58 | 76 |
在 XLD 上>10CFU 菌落无色半透明,有黑心 |
在 XLD 上 >10CFU 菌落无色 半透明, 有黑心 |
符合 |
| L 品牌 | 81 | 在 XLD 上>10CFU 菌落无色半透明,有黑心 |
符合 | ||||
| H 品牌 | 56 | 在 XLD 上>10CFU 菌落无色半透明,有黑心 |
符合 | ||||
| 大肠埃 希氏菌 ATCC25922 |
逗点 | 8 | 多不可计 |
<100 | 在 TSA 上 <100CFU | 符合 | |
| L 品牌 | 9575 | >100 | 不符合 | ||||
| H 品牌 | 5394 | >100 | 不符合 | ||||
| 1. 鼠伤寒沙门氏菌 ATCC14028+大肠埃希氏菌 ATCC25922+铜绿假单胞菌 ATCC27853 在亚硒酸盐胱氨酸增 菌液(SC)上的菌落特征:菌落无色半透明,有黑心; 2. 大肠埃希氏菌 ATCC25922 在亚硒酸盐胱氨酸增菌液(SC)上的菌落特征:在 TSA 上<100CFU; 3. 粪肠球菌 ATCC29212 在亚硒酸盐胱氨酸增菌液(SC)上的菌落特征:在 TSA 上<100CFU; |
|||||||



| 样品名称 | 质控菌株 | 厂家 | 待测培养基计数 | 菌液浓度计数(TSA) | 生长率(或特征) | 评定标准 | 结果判定 |
| 亚硫酸 铋琼脂 基础 (BS) |
鼠伤寒 沙门氏菌 ATCC14028 |
逗点 | 88 | 81 |
1.0 | PR≥0.5 |
符合 |
| L 品牌 | 110 | 1.3 | 符合 | ||||
| H 品牌 | 84 | 1.0 | 符合 | ||||
| 伤寒 沙门氏菌 CMCC50071 |
逗点 | 51 | 41 |
1.2 | PR≥0.5 |
符合 | |
| L 品牌 | 46 | 1.1 | 符合 | ||||
| H 品牌 | 24 | 0.5 | 符合 | ||||
| 大肠埃 希氏菌 ATCC25922 |
逗点 | / | / / / |
G=2 | G≤1 |
不符合 | |
| L 品牌 | / | G=1 | 符合 | ||||
| H 品牌 | / | G=4 | 不符合 | ||||
| 粪肠球菌 ATCC29212 | 逗点 | / | / / / |
G≤1 | G≤1 |
符合 | |
| L 品牌 | / | G≤1 | 符合 | ||||
| H 品牌 | / | G≤1 | 符合 | ||||
| 1. 鼠伤寒沙门氏菌 ATCC14028 在 BS 板上的菌落特征:黑色或灰绿色菌落,有金属光泽; 2. 伤寒沙门氏菌 CMCC50071 在 BS 板上的菌落特征:黑色菌落,有金属光泽; 3. 大肠埃希氏菌 ATCC25922 在 BS 板上的菌落特征:选择性 G≤1; 4. 粪肠球菌 ATCC29212 在 BS 板上的菌落特征:选择性 G≤1。 |
|||||||


| 样品名称 | 质控菌株 | 厂家 | 待测培养基计数 | 菌液浓度计数(TSA) | 生长率(或特征) | 评定标准 | 结果判定 |
| HE 琼脂 |
鼠伤寒 沙门氏菌 ATCC14028 |
逗点 | 58 | 76 |
0.7 | PR≥0.5 |
符合 |
| L 品牌 | 81 | 1.0 | 符合 | ||||
| H 品牌 | 56 | 0.7 | 符合 | ||||
| 福氏志 贺氏菌 ATCC12022 |
逗点 | 117 | 142 |
0.8 | PR≥0.5 |
符合 | |
| L 品牌 | 135 | 0.9 | 符合 | ||||
| H 品牌 | 142 | 1.0 | 符合 | ||||
| 大肠埃 希氏菌 ATCC25922 |
逗点 | / | / / / |
G=0 | G≤5 |
符合 | |
| L 品牌 | / | G=3 | 符合 | ||||
| H 品牌 | / | G=1 | 符合 | ||||
| 粪肠球菌 ATCC29212 | 逗点 | / | / / / |
0.5 | G≤1 |
符合 | |
| L 品牌 | / | G=0 | 符合 | ||||
| H 品牌 | / | G=0 | 符合 | ||||
| 1. 鼠伤寒沙门氏菌 ATCC14028 在 HE 琼脂板上的菌落特征:绿 - 蓝色菌落,有黑心; 2. 福氏志贺氏菌 ATCC12022 在 HE 琼脂板上的菌落特征:绿 - 蓝色菌落 3. 大肠埃希氏菌 ATCC25922 在 HE 琼脂板上的菌落特征:选择性 G<5,橙红色菌落,可有胆酸沉淀; 4. 粪肠球菌 ATCC29212 在 HE 琼脂板上的菌落特征:选择性 G≤1; |
|||||||



| 样品名称 | 质控菌株 | 厂家 | 待测培养基计数 | 菌液浓度计数(TSA) | 生长率(或特征) | 评定标准 | 结果判定 |
| 木糖赖氨 酸脱氧 胆盐琼脂 (XLD) |
鼠伤寒 沙门氏菌 ATCC14028 |
逗点 | 125 | 102 |
PR=1.2 | PR≥0.5 |
符合 |
| L 品牌 | 84 | PR=0.8 | 符合 | ||||
| H 品牌 | 139 | PR=1.4 | 符合 | ||||
| 福氏志 贺氏菌 ATCC12022 |
逗点 | 209 | 203 |
PR=1.1 | PR≥0.5 |
符合 | |
| L 品牌 | 172 | PR=0.8 | 符合 | ||||
| H 品牌 | 193 | PR=0.9 | 符合 | ||||
| 大肠埃 希氏菌 ATCC25922 |
逗点 | / | / / / |
G=3.5 | G<5 |
符合 | |
| L 品牌 | / | G=1 | 符合 | ||||
| H 品牌 | / | G=5.5 | 不符合 | ||||
| 金黄色 葡萄球菌 ATCC6538 |
逗点 | / | / / / |
G=0 | G≤1 |
符合 | |
| L 品牌 | / | G=0 | 符合 | ||||
| H 品牌 | / | G=0 | 符合 | ||||
| 1. 鼠伤寒沙门氏菌 ATCC14028 在 XLD 板上的菌落特征:黑色菌落; 2 福氏志贺氏菌 CMCC(B)51572 在 XLD 板上的菌落特征:无色菌落,无黑心; 3. 大肠埃希氏菌 ATCC 25922 在 XLD 板上的菌落特征:黄色菌落,选择性 G<5 4. 金黄色葡萄球菌 ATCC6538 在 XLD 上的菌落特征:选择性 G≤1; |
|||||||


| 样品名称 | 质控菌株 | 厂家 | 待测培养基计数 | 参比培养基计数(TSA) | 生长率(或特征) | 评定标准 | 结果判定 |
| 沙门氏菌 显色 培养基 |
鼠伤寒沙门氏菌 ATCC14028 | 逗点 | 45 | 76 | 0.5 | PR≥0.5 | 符合 |
| H 品牌 | 64 | 0.8 | PR≥0.5 | 符合 | |||
| 大肠埃希氏菌 ATCC25922 | 逗点 | / | / | 蓝色菌落 | 蓝色菌落 | 符合 | |
| H 品牌 | / | 蓝色菌落 | 蓝绿色菌落 | 符合 | |||
| 奇异变形杆菌 CMCC(B)49005 | 逗点 | / | / | 无色,淡紫色 | 无色,淡褐色菌落 | 符合 | |
| H 品牌 | / | / | 无色菌落 | 无色菌落 | 符合 | ||
| 粪肠球菌 ATCC29212 |
逗点 | / | / | G=0 | G≤1 | 符合 | |
| H 品牌 | / | / | G=0 | 符合 | |||
| 1. 鼠伤寒沙门氏菌 ATCC14028 在沙门氏菌显色培养基板上的菌落特征:品(紫)红色菌落; 2. 大肠埃希氏菌 ATCC25922 在沙门氏菌显色培养基板上的菌落特征:按说明书判定; 3. 奇异变形杆菌 CMCC(B)49005 在沙门氏菌显色培养基板上的菌落特征:按说明书判定; 4. 粪肠球菌 ATCC29212 在沙门氏菌显色培养基板上的菌落特征:选择性 G≤1; |
|||||||

| 样品名称 | 质控菌株 | 厂家 | 待测培养基计数 | 生长率(或特征) | 评定标准 | 结果判定 |
| 三糖 铁琼脂 (TSI) |
大肠埃 希氏菌 ATCC25922 |
逗点 | / | 生长良好,A/A;产气;不产硫化氢 | 生长良好,A/A; 产气;不产硫化氢 | 符合 |
| L 品牌 | / | 生长良好,A/A;产气;不产硫化氢 | 符合 | |||
| H 品牌 | / | 生长良好,A/A;产气;不产硫化氢 | 符合 | |||
| 炎沙门 氏菌 CMCC(B) 50335 |
逗点 | / | 生长良好,K/A;产气;产硫化氢 | 生长良好,K/A; 产气;产硫化氢; | 符合 | |
| L 品牌 | / | 生长良好,K/A;产气;产硫化氢 | 符合 | |||
| H 品牌 | / | 生长良好,K/A;产气;产硫化氢 | 符合 | |||
| 福氏志 贺氏菌 ATCC12022 |
逗点 | / | 生长良好,K/A;不产气;不产硫化氢 | 长良好,K/A; 不产气;不产硫化氢 |
符合 | |
| L 品牌 | / | 生长良好,K/A;不产气;不产硫化氢 | 符合 | |||
| H 品牌 | / | 生长良好,K/A;不产气;不产硫化氢 | 符合 | |||
| 铜绿假 单胞菌 ATCC27853 |
逗点 | / | 生长良好,K/K;不产气;不产硫化氢 | 生长良好,K/K; 不产气;不产硫化氢 |
符合 | |
| L 品牌 | / | 生长良好,K/K;不产气;不产硫化氢 | 符合 | |||
| H 品牌 | / | 生长良好,K/K;不产气;不产硫化氢 | 符合 | |||
| 1. 大肠埃希氏菌 ATCC25922 在三糖铁琼脂 (TSI) 上生长良好,A/A;产气;不产硫化氢; 2. 肠炎沙门氏菌 CMCC(B)50335 生长良好,K/A;产气;产硫化氢; 3. 福氏志贺氏菌 ATCC12022 生长良好,K/A;不产气;不产硫化氢; 4. 铜绿假单胞菌 ATCC27853 生长良好,K/K;不产气;不产硫化氢; |
||||||
